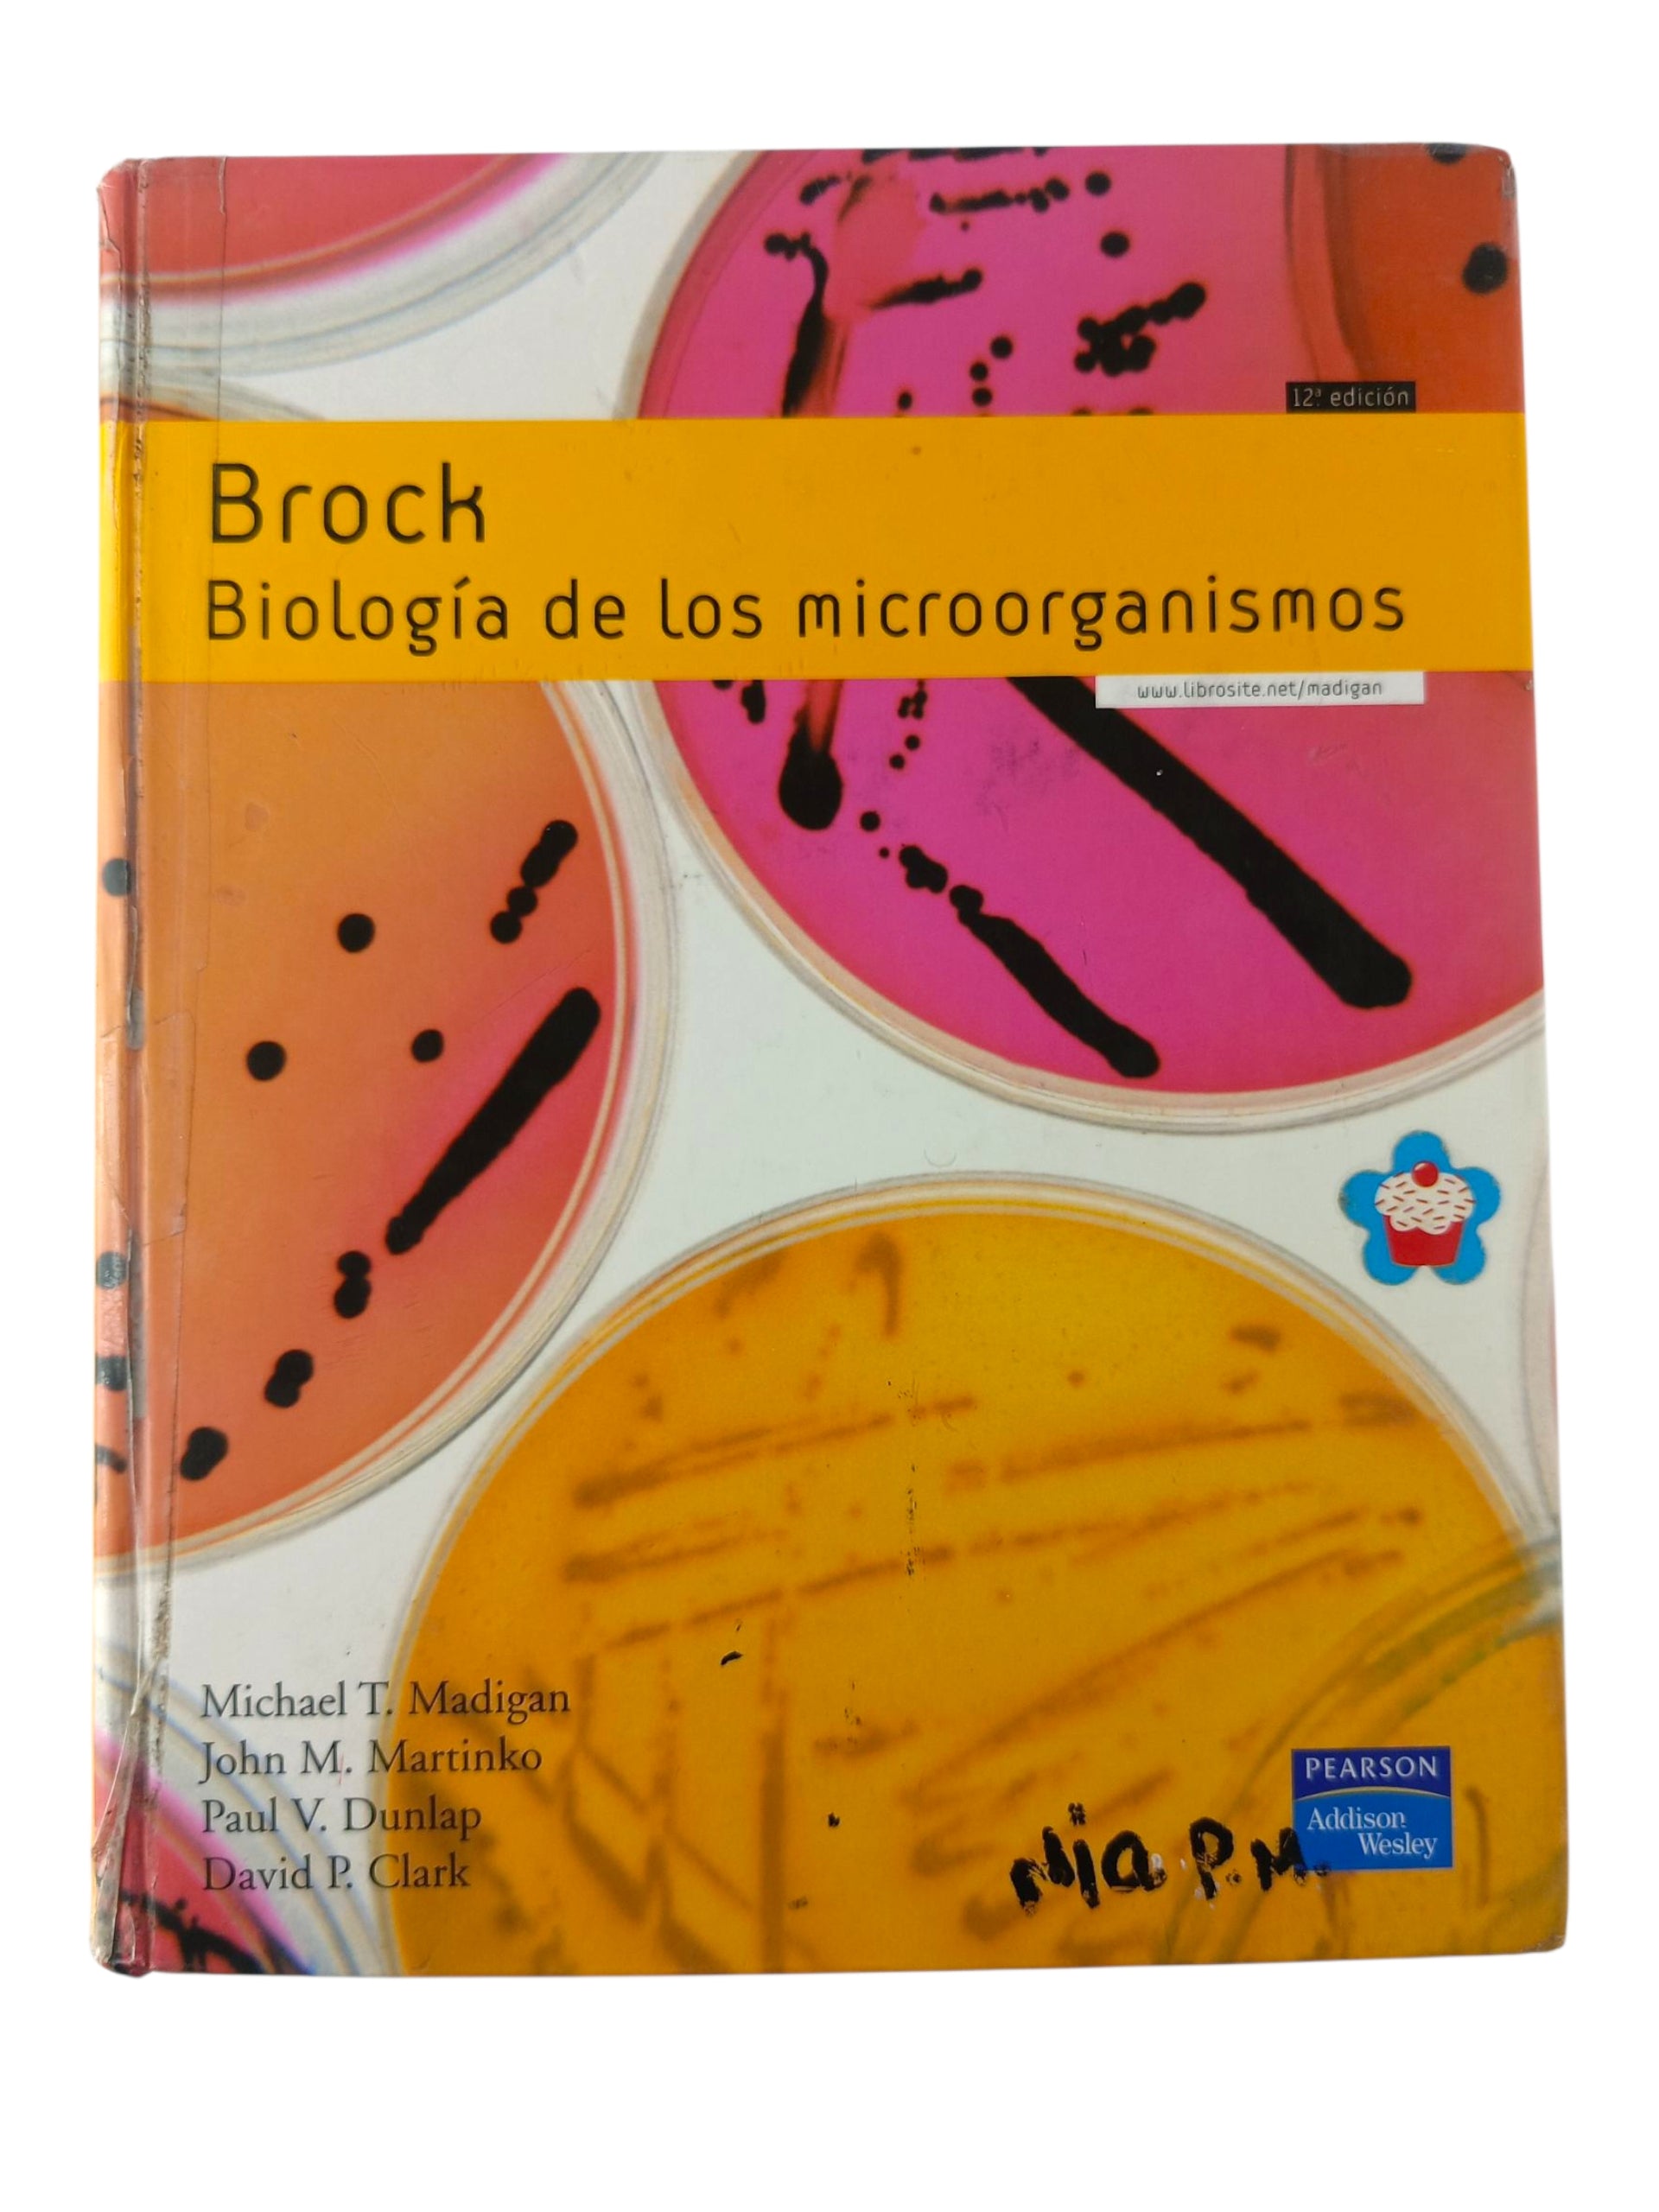

John Martinko
Brock Biologia de los microorganismos 12va Ed
Brock Biologia de los microorganismos 12va Ed
Precio habitual
$230.000
Precio habitual
Precio de oferta
$230.000
Precio unitario
/
por
Estado: Usado 8/10
Los gastos de envío se calculan en la pantalla de pago.
Característica:
Biología
No se pudo cargar la disponibilidad de retiro
Share
Los autores de este libro están orgullosos de presentar su duodécima edición. Un libro que cumple casi cuarenta años y nunca ha variado sus objetivos principales: presentar los principios básicos de la microbiología de un modo claro y apasionante. Biología de los microorganismos es un libro de microbiología tanto para estudiantes que comienzan como para investigadores experimentados; presenta una mezcla adecuada entre principios básicos y detalles
1300 Páginas - Tapa dura
Código: 9788478290970
Ver todos los detalles